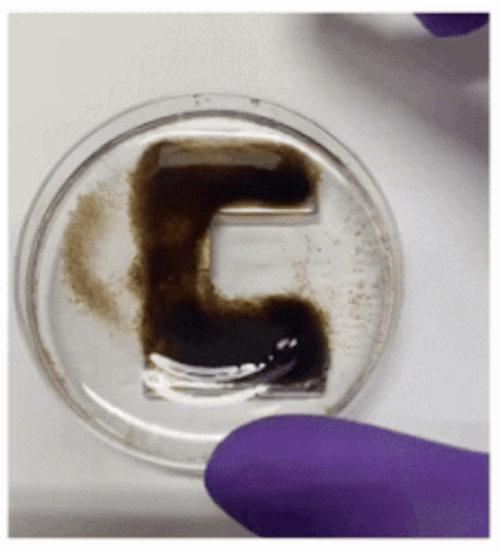

Thursday, June 19, 2025
Programmable droplets offer new tools for water treatment
A Waterloo-led research team creates “programmable” droplets with potential usage in wastewater treatment and carbon capture
The new process, called droplet templating, uses nanoparticles to form a robust outer shell around each droplet, enabling the creation of lightweight, porous aerogel beads. This breakthrough opens the door to next-generation soft materials with promising applications in carbon capture and wastewater treatment.
Go to Waterloo News: How to suspend one liquid inside another for the full story.
The aerogel bead droplets are filled with magnetic particles that can be used to shield against electromagnetic waves. A magnet under the Petri dish helps to attract the droplets into the 'C' position. (University of Waterloo)